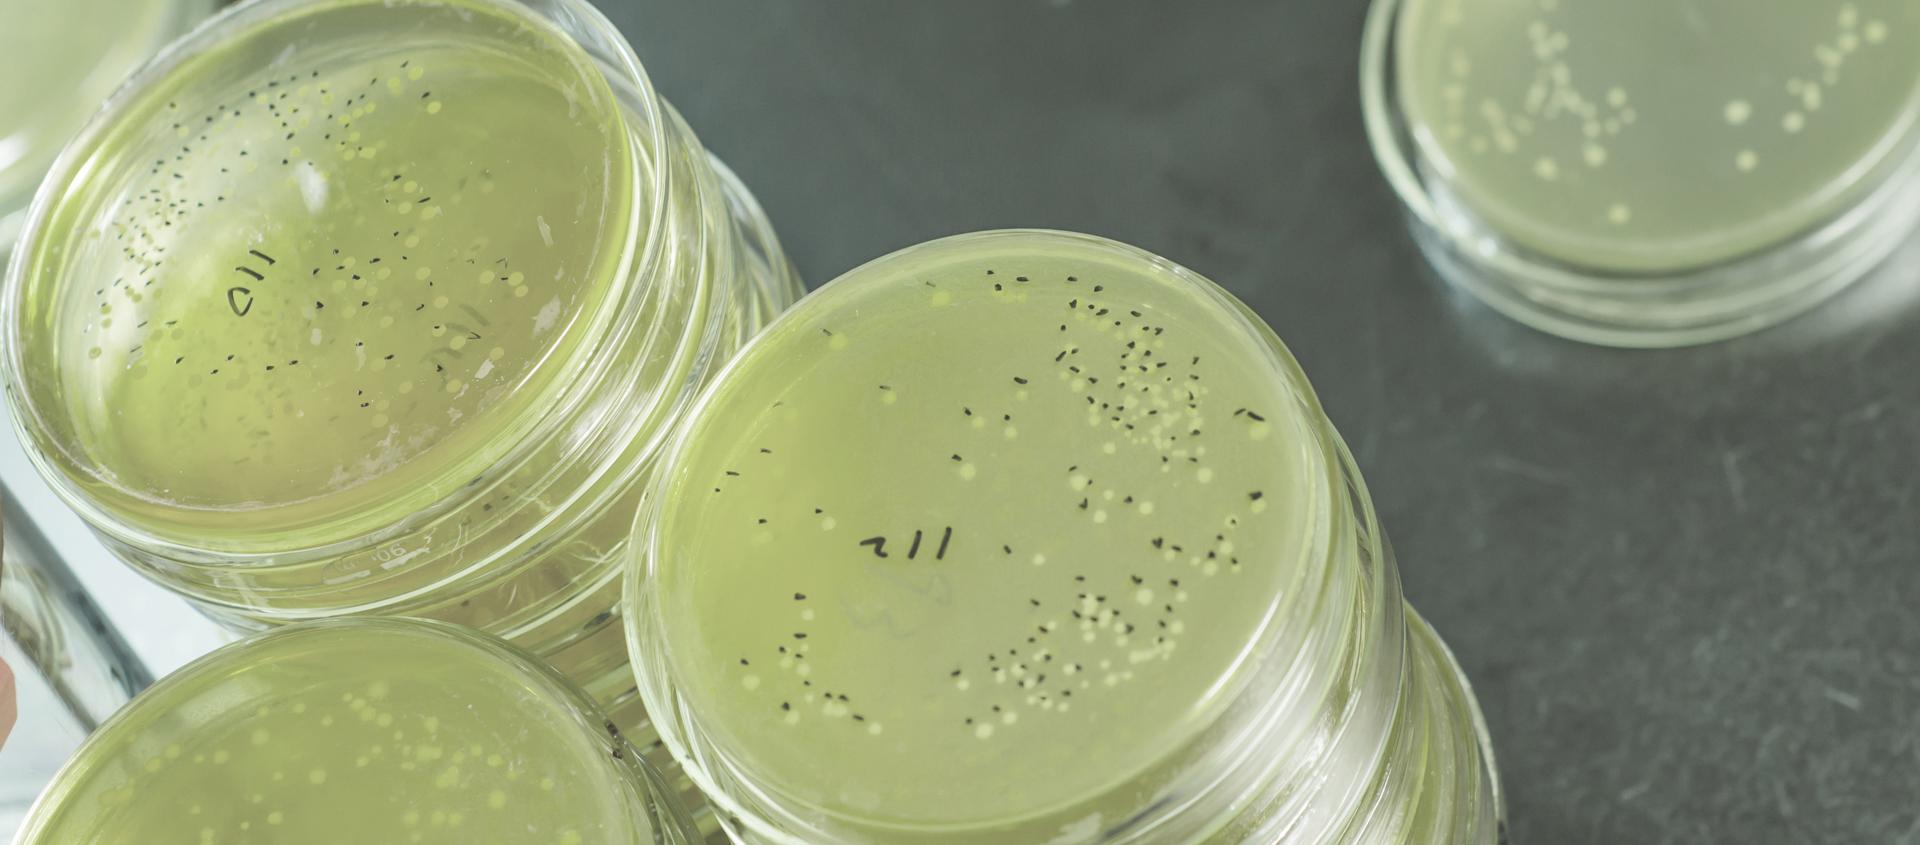

Take control of Legionella in four steps
Bacteria, including Legionella, are naturally occurring in water. Due to the seriousness related to Legionella, relevant precautions must be implemented to safely handle the risk of infections.
In cold water systems, the following points are critical:
- Avoid temperatures between 20 – 50° Celsius
- Prevent stagnant and recycled water
- Minimize residence time, i.e. the amount of time the water is kept within the system
- Prevent high concentrations of nutrients by applying e.g. RO treatment of the water
To design and operate a reliable air humidification system, and to ensure that the water complies with drinking water standards, these factors needs to be implemented as a part of the solution.
Legionella bacteria are common, and naturally occurring in environmental water sources, and can become a risk when entering human-made water systems. Legionella, however, only constitutes a risk when propagation has been present.
In 2004, the Danish environmental authorities issued a detailed report about the overall risk of Legionella in installations using drinking water. In the following, we will break down the Legionella issue and how to prevent it by maintaining any water system correctly.


The Legionella bacteria
Legionnaires disease is caused by bacteria belonging to the Legionellaceae family, which includes over 40 different species of bacteria and over 70 serogroups. However, it is the Legionella pneumophila that is the frequent cause of legionnaires disease in humans.
Legionella pneumophila flourishes in water within the 30 to 40° Celsius temperature range but is known to survive and even multiply in a larger interval.
In order for Legionella bacteria to thrive, the temperature range needs to be just right, but the bacteria strain also requires nutrients such as the biofilm that typically forms in pipes and water conduits (biological percolator soil).
In short, Legionella pneumophila likes to live and grow where lukewarm, stagnant water with high nutrient levels are common; precisely the type of water installations that are widely used in homes and in industrial installations.
The issue with Legionella
The presence of Legionella bacteria can cause various types of infections, which, in some cases, can be lethal. That is why the potential threat of Legionella should not be taken lightly. But with proper design and maintenance, the risk of Legionella propagation in high-pressure air humidifying systems is extremely low.
In the report by the Danish environmental authorities, the drinking water in Denmark was found to not represent a risk because of the overall quality of the water and the temperature being too low for propagation of Legionella.
In order to prevent growth of Legionella bacteria in any water-related system, the following must be observed:
- Avoid temperatures between 20-50° Celsius
- Prevent stagnant and recycled water (minimizing residence time)
- Prevent high concentrations of nutrient
Airtec® hygienic design
Our processes and guidelines are constructed and maintained in accordance with ISO 9001, 14001 and 22000 – Accredited by Norske Veritas.
In Airtec® systems, Legionella is not an issue - our hygienic design philosophy centers on the following:
- Cold water system
- Drinking water standard as defined in the Airtec® SystemGuide guideline
- Confirmed by accredited water report
- Hygienic rinse system: If system standby time exceeds 6 hours rinse is activated
- FRQ high pressure pump control
- No by-pass no heat accumulation
- Small water pipes
- RO water filtration
- De-mineralization filter removes up to 98 % of solids and bacteria
- Installation by authorized engineers from Airtec® or Airtec® partners
- Maintenance: AirtecCare™ twice per year
- Customer check-up procedure
- Implementing customer weekly check-up procedure in accordance with user manual
Please note:
UV radiation elements are often used for disinfection in humidifiers. The main concern is that this does not affect amoebas. Therefore such units will provide heat to the water with no proven disinfective effect. Airtec does not recommend the use of this. UV has only limited documentation for the positive effects and has not achieved the approval of the authorities.